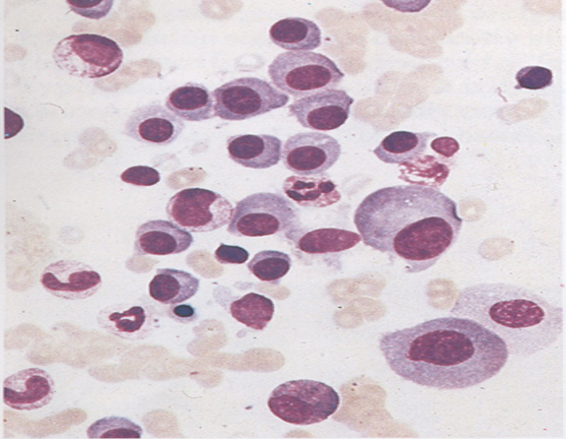

Novos horizontes para tratar o Mieloma Múltiplo no SUS
Dores nas costas, fraqueza, infecções por repetição, fraturas frequentes… Por serem sintomas que facilmente podem ser confundidos com os de outras doenças, muitas vezes o Mieloma Múltiplo demora a ser diagnosticado. Os primeiros medicamentos lançados duas décadas atrás para tratar a doença tinham pouca eficácia, principalmente em diagnósticos mais avançados. Com isso, a sobrevida dos pacientes era muito limitada.
Nos últimos anos, felizmente, vivenciamos um grande avanço no tratamento do Mieloma Múltiplo. Atualmente, há uma ampla variedade de medicamentos que podem ser combinados, ao longo da jornada terapêutica. Hoje, os pacientes apresentam uma sobrevida longa, inclusive atingindo a cura funcional. No entanto, apesar do cenário positivo, o acesso aos medicamentos inovadores ainda é uma barreira para grande parte da nossa população.
“Nossa prioridade, neste momento, é diminuir a distância entre o acesso público e privado a esses avanços. Se conseguirmos isso, a qualidade de vida será uma realidade para um maior número de brasileiros com a doença” – ressaltou o hematologista Angelo Maiolino, professor do Departamento de Clínica Médica da Faculdade de Medicina da UFRJ e pesquisador membro do Programa de Oncobiologia.
Fornecendo uma relevante contribuição para trazer luz à discussão sobre a inclusão da lenalidomida – um medicamento inovador para tratar o Mieloma Múltiplo – no arsenal terapêutico do Sistema Único de Saúde (SUS), recentemente, o grupo de pesquisa do Prof. Angelo Maiolino, juntamente com o Laboratório de Citometria de Fluxo do IPPMG/ UFRJ , coordenado pela Profª Elaine Sobral, e colaboradores internacionais da Espanha, publicou um artigo (*) na revista científica Cancers, em edição especial voltada ao Mieloma Múltiplo.

Lenalidomida x Talidomida
O estudo comparou o desfecho do tratamento da doença com fármacos disponíveis no sistema público de saúde (talidomida) e no sistema privado (lenalidomida). Demonstrou que os pacientes do sistema privado que receberam a lenalidomida tiveram um desfecho superior, tanto na obtenção da doença residual mínima negativa quanto na sobrevida global, quanto se comparada aos pacientes do SUS que não receberam a lenalidomida, sendo tratados com a talidomida.
“Os mecanismos de ação da lenalidomida e da talidomida são diferentes. Ambos são imunomoduladores mas têm diferenças fundamentais e uma, particularmente, é muito importante. A eficácia da lenalidomida é muito maior, ela é muito mais potente como medicamento e não provoca neuropatia periférica, uma complicação muito comum em consequência do uso da talidomida” – pontuou o pesquisador do Programa de Oncobiologia.
“Essa limitação da neuropatia periférica da talidomida acarreta que o paciente não consiga usar o medicamento por um período muito longo de tempo, enquanto que a lenalidomida consegue ser administrada por períodos maiores, três, quatro anos… Ao utilizar por um período mais longo e pela lenalidomida ter uma atividade mais eficaz como fármaco, o paciente consegue resultados superiores como, por exemplo, mostramos no artigo da Cancers, na manutenção pós-transplante autólogo” – completou Maiolino, que é vice-presidente da Associação Brasileira de Hematologia, Hemoterapia eTerapia Celular (ABHH).
Principais avanços terapêuticos no tratamento
O Mieloma Múltiplo é um tipo de câncer no sangue, uma neoplasia hematológica, que se origina a partir do plasmócito – que é a célula (glóbulo branco) que produz os anticorpos. Quando o plasmócito se torna maligno, ocorre uma alteração clonal, ele se prolifera, infiltra na medula, podendo causar algumas tumorações chamadas plasmocitomas. A doença acarreta a produção de uma proteína alterada – proteína monoclonal – ao invés de um anticorpo normal.
Nas últimas décadas, as novas terapias-alvo no tratamento Mieloma Múltiplo aumentaram a sobrevida dos pacientes em cerca de 50%, sustentando o papel do sistema imune no controle da doença. Entre as chamadas drogas alvo, há três (3) categorias principais:
1. os inibidores do proteassoma que são representados pelo bortezomibe e carfilzomibe e o ixazomibe (uso oral);
2. os imunomoduladores, inicialmente a talidomida, depois a lenalidomida e a pomalidomida que já estão aprovados no Brasil;
3. os anticorpos monoclonais de vários tipos, o principal deles hoje ainda é o anti-CD38, chamado daratumumab e isatuximabe. Recentemente, ocorreu aprovação de um novo anticorpo monoclonal específico chamado teclistamabe.

“Houve um enorme avanço. Nenhum desses medicamentos existia há mais de 15 anos. O uso deles, em combinação, de primeiras linhas, e também na volta do doença (recidiva) representa uma grande melhora do desfecho, na sobrevida desses pacientes, de modo que consideramos que alguns de nossos pacientes podem não ter uma cura, com o desaparecimento completo da doença, mas podem pelo menos ter uma cura funcional” – ponderou o hematologista.
Segundo o pesquisador, com o acesso ao tratamento com esses medicamentos inovadores os pacientes têm a chance de viver 10, 15, 20 anos e, eventualmente, vir a falecer de outra condição, senão o mieloma.
Uso da citometria de fluxo para análise do microambiente tumoral
Atualmente, a maioria dos estudos na área de câncer são voltados para conhecer a célula tumoral. Entretanto, existe a hipótese de que seria necessário um “solo fértil” para que o câncer se desenvolvesse. E no Mieloma Múltiplo não é diferente. Por isso, é extremamente importante aprofundar os estudos da composição e das características do microambiente onde a célula tumoral se prolifera para compreender a patogênese da doença.
Para desenvolver suas pesquisas o Prof. Angelo Maiolino e equipe fazem uso da citometria de fluxo como ferramenta para estudo do microambiente tumoral no Mieloma Múltiplo. Por sua relevância científica e importância para saúde pública, este estudo recebeu apoio financeiro da Fundação do Câncer, no âmbito do Edital de Pesquisa 2022 do Programa de Oncobiologia.
A citometria de fluxo de nova geração já tinha uma grande contribuição para diagnóstico do Mieloma Múltiplo, mas agora a ferramenta é usada, principalmente, na avaliação do que é chamado de doença residual mínima. “Nesse estudo a resposta do tratamento é avaliada pelo desaparecimento da proteína monoclonal. Com essa técnica conseguimos aprofundar, ainda mais, a avaliação de resposta, ou seja, o desaparecimento completo dos plasmócitos clonais ” – explicou o pesquisador.
Segundo o especialista, se não tiver um microambiente doente que favoreça a proliferação do plasmócito, a doença não se prolifera, então há uma possibilidade, ao avaliar o microambiente de, futuramente, algumas dessas drogas (os inibidores de proteassoma, os imunomoduladores e os inibidores monoclonais CD-38) atuarem (hoje algumas já atuam), não somente no plasmócito, mas também no microambiente estimulando as células do sistema imune atacar o plasmócito maligno e fazer com que haja uma inibição da proliferação plasmocitária.
*Referência:
Salgado, A.B.d.S.; Magalhães, R.J.P.; Pontes, R.M.; Barbosa, E.d.S.; Flores-Montero, J.; Sanoja-Flores, L.; Land, M.G.P.; Pimenta, G.; Dutra, H.d.S.; Costa, E.S.; Orfao, A.; Maiolino, A. Lenalidomide Maintenance and Measurable Residual Disease in a Real-World Multiple Myeloma Transplanted Population Receiving Different Treatment Strategies Guided by Access to Novel Drugs in Brazil. Cancers. 2023, 15, 1605. https://doi.org/10.3390/cancers15051605
Por Lúcia Beatriz Torres, jornalista de Ciência, responsável pelo Núcleo de Divulgação do Programa de Oncobiologia. Publicado em 09/05/2023.



Deixe um comentário